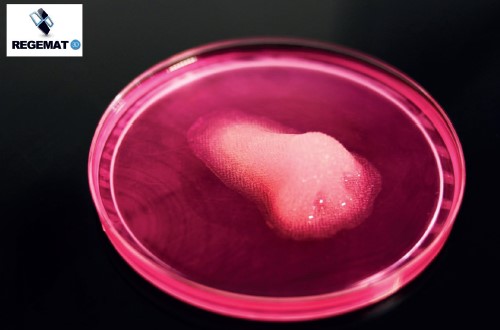

Bioimpresión 3D y biofabricación de tejidos y órganos en el laboratorio
Científicos de todo el mundo trabajan a contrarreloj para encontrar solución a las patologías de las personas y alargar la vida y la calidad de la misma. El envejecimiento y los procesos degenerativos tisulares que lo causan no han sido comprendidos hasta la fecha en su totalidad, y la necesidad de estudiar las células en entornos 3D similares a los que se encuentran en un organismo es un factor clave para encontrar soluciones.

